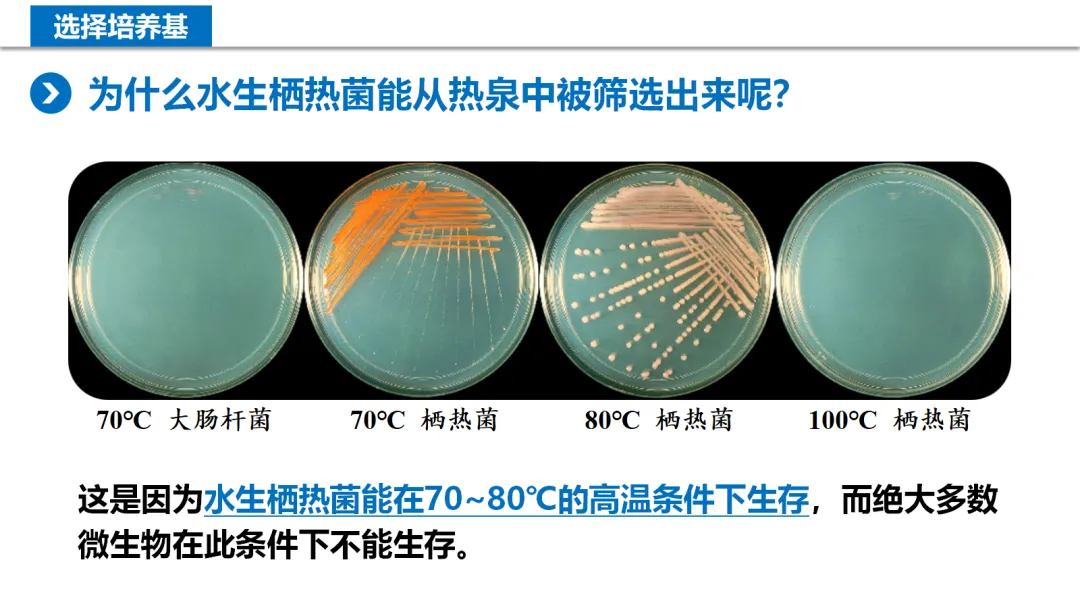
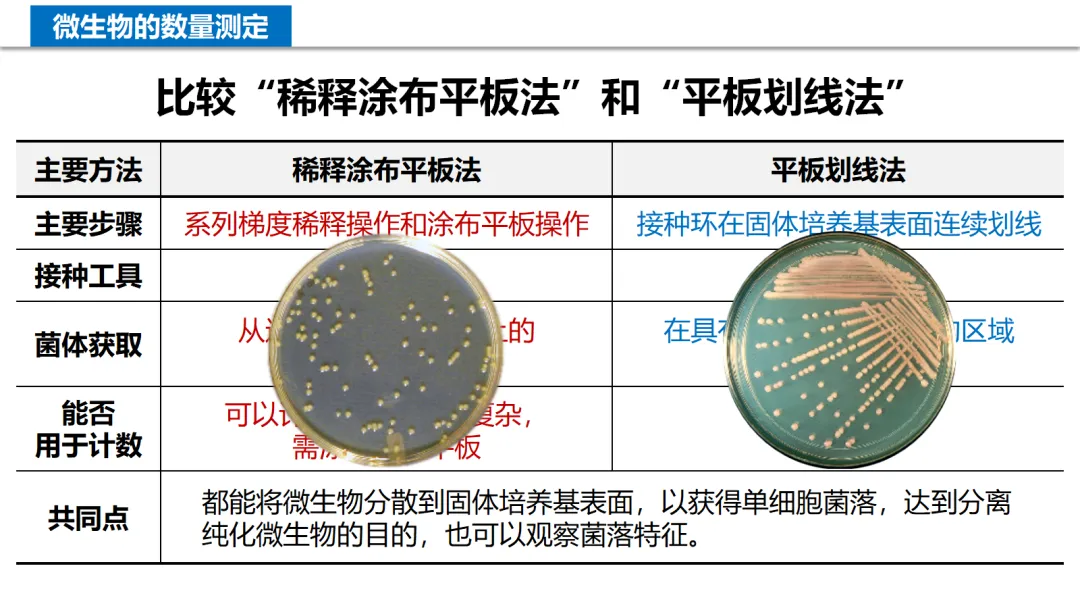

【PPT课件】高中生物学选择性必修3:§1.2 微生物的培养技术及应用(2)微生物的选择培养和计数 | 新课课件(2026版)
- 2026-06-01 05:42:42
【PPT课件】高中生物学选择性必修3:§1.2 微生物的培养技术及应用(2)微生物的选择培养和计数 | 新课课件(2026版)上一篇:
1.2 微生物的培养技术及应用 (2)微生物的选择培养和计数 【共1-2课时】 说明:教学目标、教学重难点等省略,详见上述“相关篇”。PPT分享结尾处附获取方式。
以下为PPT课件的视频播放完整版[有配音,请注意周围环境]:
以下为PPT课件(本课件为1-2个课时的内容,共36页)的幻灯片展示: 



































--- PPT可编辑完整版课件获取方式 --- 
点击下方的公众号名片发送:XB3KJ122 免费下载获取 

添加下面的微信(长按图片,识别二维码后可添加微信)详询(微信号:Biosky_CN): 
推荐阅读: 高中生物学《必修1》资料大全高中生物学《必修2》资料大全 高中生物学《选择性必修1》资料大全 高中生物学《选择性必修2》资料大全 高中生物学《选择性必修3》资料大全 免费下载 | 高中生物学试卷集合(1) 免费下载 | 高中生物学试卷集合(2) 免费下载 | 高中生物学教材电子书(含教师教学用书) 高中生物学教师应聘/教资面试试讲专项资料 高中生物学必修1-无生试讲视频合辑 高中生物学必修2-无生试讲视频合辑 普通高中学业水平合格性考试生物学复习资料(必修1、2) 高考真题 | 近几年全国及各省高考生物学真题试卷 | 在线答题
特别说明: 本公众号发布的视频、音频、文字等资料来源于国家中小学智慧教育平台、互联网、已出版书籍等渠道,仅作为学习交流使用,不作为商业用途。我们尊重原创,并对原创者表示感谢。若不慎侵犯了您的合法权益,请联系我们及时处理,谢谢!
【PPT课件】高中生物学选择性必修3:§1.2 微生物的培养技术及应用(1)微生物的基本培养技术 | 新课课件(2026版)
相关篇:
教学设计 | 1.2 微生物的培养技术及应用 | 人教版高中生物学选择性必修3
新课课件 | 高中生物学《选必3》:§1.2 微生物的培养技术及应用(2)微生物的选择培养和计数(2025版)
已关注
关注
重播 分享 赞

视频合辑 | 高中生物学 优质课/示范课
本文来自网友投稿或网络内容,如有侵犯您的权益请联系我们删除,联系邮箱:wyl860211@qq.com 。
